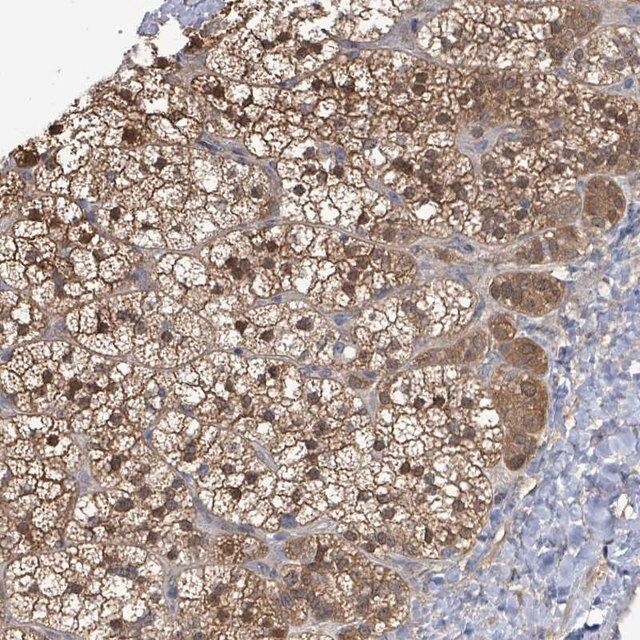

дә§е“Ғд»Ӣз»Қпјҷь/div>
дә§е“ҒиҜҙжҳҺ
дёҖиҲ¬жҸҸиҝ?/p>
Anti-Pentraxin 3 antibody, Mouse monoclonal (mouse IgG1 isotype) is derived from the PTX3-5 hybridoma, produced by the fusion of mouse myeloma cells and splenocytes from BALB/c mouse immunized with recombinant human pentraxin 3 protein expressed in HEK-293 cells. Pentraxin 3 (PTX3), also called tumor necrosis factor inducible gene 14 protein (TSG-14), is a highly glycosylated secreted protein usually found as covalently-bound homooctamers. PTX3 belongs to the pentraxin subfamily, sharing the C-terminal domain with short pentraxins and contains a unique N-terminal domain. PTX3 is majorly present in monocytes, macrophages, fibroblasts, endothelial cells and adipocytes. It is an acute-phase protein mapped to human chromosome 3q25.32.
зү№ејӮжҖ?/p>
Anti-Pentraxin 3 antibody, Mouse monoclonal recognizes both glycosylated and non-glycosylated human PTX3.
е…Қз–«еҺһь/p>
recombinant human Pentraxin 3 protein expressed in HEK-293 cells
еә”з”Ё
Anti-Pentraxin 3 antibody, Mouse monoclonal may be used in immunoblotting and immunoprecipitation.
з”ҹеҢ–/з”ҹзҗҶдҪңз”Ё
Pentraxin 3 (PTX3) is released in response to primary inflammatory signals, such as toll-like receptor engagement, tumor necrosis factor ҰБ (TNFҰБ) and interleukin 1ҰВ (IL-1ҰВ). It regulates innate resistance to pathogens, inflammatory reactions, possibly clearance of self-components and female fertility. PTX3 acts as a soluble pathogen recognition receptor and aids resistance against pathogens. It participates in the removal of apoptotic cells during an immune response. PTX3 associates with complement factor H and associates with synovial fluid in rheumatoid arthritis and also in conditions of sepsis. PTX3 is suppressed by pitavastatin, making it a biomarker for inflammatory cardiovascular disease.
еӨ–еҪў
Solution in 0.01 M phosphate buffered saline, pH 7.4, containing 15 mM sodium azide.
еӮЁеӯҳеҸҠзЁіе®ҡжҖ?/p>
For continuous use, store at 2вҖ? в„ for up to one month. For extended storage, freeze in working aliquots. Repeated freezing and thawing is not recommended. If slight turbidity occurs upon prolonged storage, clarify the solution by centrifugation before use. Working dilution samples should be discarded if not used within 12 hours.
е…ҚиҙЈеЈ°жҳҺ
Unless otherwise stated in our catalog, our products are intended for research use only and are not to be used for any other purpose, which includes but is not limited to, unauthorized commercial uses,in vitrodiagnostic uses,ex vivoorin vivotherapeutic uses or any type of consumption or application to humans or animals.
еҹәжң¬дҝЎжҒҜ
дә§е“ҒжҖ§иҙЁ
| иҙЁйҮҸж°ҙе№і |
200 |
| з”ҹзү©жқҘжәҗ |
mouse |
| жҠ—дҪ“еҪўејҸ |
purified from hybridoma cell culture |
| antibody product type |
primary antibodies |
| е…ӢйҡҶ |
PTX3-5, monoclonal |
| еҪўејҸ |
buffered aqueous solution |
| еҲҶеӯҗйҮҺь/td> |
~47 kDa |
| species reactivity |
human |
| жө“еәҰ |
~1 mg/mL |
| technique(s) |
immunoblotting: 0.5-1 ҰМg/mL using purified recombinant human Pentraxin 3 protein
immunoprecipitation (IP): 1-2 ҰМg/test using lysate of HEK-293T cells over-expressing human Pentraxin 3 |
| еҗҢдҪҚзҙ?дәҡеһӢ |
IgG1 |
| UniProtзҷ»и®°еҸ¶ь/td> |
P26022 |
| иҝҗиҫ“ |
dry ice |
| еӮЁеӯҳжё©еәҰ |
?20в„Ӯь/td> |
| Gene Information |
human ... PTX3(5806) |
е®үе…ЁдҝЎжҒҜ
| еӮЁеӯҳеҲҶзұ»д»Јз Ғ |
12 - Non Combustible Liquids |
| й—ӘзӮ№(F) |
Not applicable |
| й—ӘзӮ№(C) |
Not applicable |
 m.cnreagent.com
m.cnreagent.com